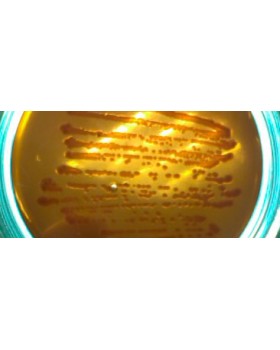
среда Левина -ГРМ (0.25 кг)

колба мерная ПМ 2-100
Мерная маленькая лабораторная колба с массивной пробкой из прочного
стекла и шлифом горловины (исполнение 2). Изделие используется в широком спектре
научно-исследовательских работ для отмеривания жидкостей определенных объемов. Например,
мерная колба является важным инструментом при приготовлении растворов.
Горловина сосуда имеет цилиндрическую форму, на ее боковую поверхность
нанесена кольцевая метка. Колба мерная с притертой пробкой 2-100 ПМ имеет шлиф горлышка
(шлиф-муфта), заменяемый конус КШ. Материал – прозрачное стекло высокого качества.
Класс точности изделия второй, выпускается она в соответствии
с ГОСТ 1770-74.
Характеристики
Объем, мл
100
Шлиф
10/19
Страна
Россия
Вы смотрели
Интересные факты
История бенгальских огней
- 23.01.2025
Бенгальские огни – это яркие атрибуты праздника, неразрывно...
Подробнее..Почему, когда вливаешь воду в стакан, она оказывается на столе?
- 23.01.2025
Вы, вероятно, замечали, как при наливании жидкости...
Подробнее..Что такое аналемма?
- 22.01.2025
Возможно, вы обращали внимание на старинных глобусах на таинственную...
Подробнее..Теги: колба мерная ПМ 2-100
Можете добавлять сколько угодно вкладок (табов), с любой информацией : текст, фото, видео и т.д.